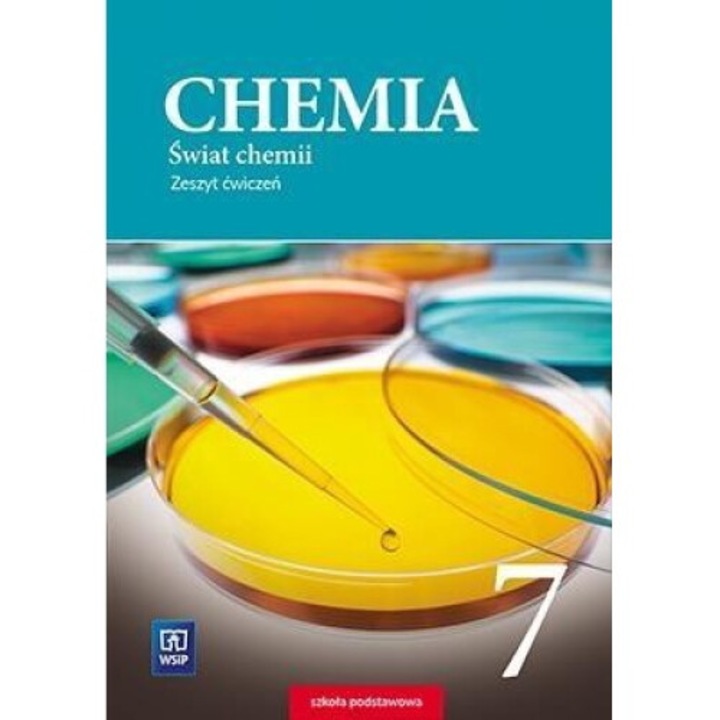
Chemia SP 7 Swiat chemii, Dorota Lewandowska, Anna Warchol, 2017

"chimie clasa 9"
699 rezultate.
Esti in categoria "Manuale si auxiliare scolare"
Poti incerca și următoarele categorii:
-
 Manuale si auxiliare scolare(699 produse)
Manuale si auxiliare scolare(699 produse) -

Caiet De Vacanta - Clasa Pregatitoare - Gabriela Barbulescu, Nicoleta Stanica
ultimul produs in stoc
24,73 Lei
Super Pret

Super Pret
Caiet De Vacanta - Clasa 3 - Gabriela Barbulescu, Olguta Schiopu
ultimul produs in stoc
24,79 Lei
-7%
39,14 Lei
36,36 Lei
Super Pret
28,46 Lei
30,00 Lei

Nowa chemia to jest chemia zbior zadan dla klas 1-4 liceum i technikum zakres rozszerzony, Opracowanie zbiorowe, 2024
în stoc
 Rate 0% dobanda cu MyWallet
Rate 0% dobanda cu MyWallet
136,99 Lei

Chimie C4. Manual. Clasa a XI-a - Luminita Ursea, Cornelia Cercasov
ultimul produs in stoc
21,15 Lei

Chimie, Manual pentru liceu si tehnicum clasa a 2-a, Editia 2023, WSiP
în stoc
 Rate 0% dobanda cu MyWallet
Rate 0% dobanda cu MyWallet
329,99 Lei
34,00 Lei

Bright Ideas 5 AB with Online Practice, Oxford, 2018, 120 pagini, coperta moale, 275x220x9mm
în stoc
 Rate 0% dobanda cu MyWallet
Rate 0% dobanda cu MyWallet
135,78 Lei
Super Pret
38,00 Lei
Super Pret
64,38 Lei
6,09 Lei
PRP: 82,28 Lei
71,00 Lei
-5%
77,77 Lei
73,88 Lei

Aurul si argintul. Procese si tehnologii, Alexandru Barbu
ultimele 2 produse
 Rate 0% dobanda cu MyWallet
Rate 0% dobanda cu MyWallet
195,37 Lei

Chimie. Clasele a VII-a, a VIII-a - Luminita Irinel DoicinSilvia GirtanMaria Dragomir
ultimul produs in stoc
41,34 Lei
-7%

Crazy Season
Probleme De Matematica - Clasele 9-12 - Dan Seclaman
ultimele 3 produse
53,89 Lei
49,92 Lei
de la 68,02 Lei
Linkuri utile:
Becuri
Monitoare LED
Stickere decorative
Mobilier camera copii
Accesorii auto tuning
Televizoare
Aplice si plafoniere
Manuale si auxiliare scolare
Masini de spalat vase
Paturi
Lustre si pendule
Masini de spalat rufe
Boilere
Folii protectie telefoane
Veioze si lampi
Piese auto
Telefoane Mobile
Aparate de aer conditionat
Instalatii de Craciun
Oglinzi si mobilier baie